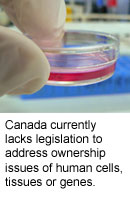

Strategy for Hematopoietic Progenitor Enrichment

June 2014 | mcewencentre.com
The generation of hematopoietic stem cells (HSCs) from human pluripotent stem cells (hPSCs) in vitro would represent a major advance in stem cell biology as it would provide an unlimited supply of these cells for transplantation for the treatment of hematological diseases. To be able to derive HSCs from hPSCs, it is essential to recapitulate the developmental pathway in the culture dish that leads to their formation in the early embryo.
The embryonic hematopoietic system is composed of two distinct developmental programs known as primitive and definitive. The primitive program gives rise to primitive erythroblasts, macrophages and megakaryocytes, while the definitive program generates the entire spectrum of blood cells found in the adult, including HSCs. As cells from both programs develop in the hPSC differentiation cultures, important first steps in the search for the HSC are the development of marker sets to distinguish primitive and definitive hematopoietic progenitors, and the identification of signaling pathways that regulate their specification.
A study published in Nature Biotechnology by McEwen Centre Director Dr. Gordon Keller has moved researchers one step closer to being able to generate HSCs in vitro as it identifies a marker, CD235a, that distinguishes primitive and definitive hematopoiesis and it demonstrates that Wnt-β-catenin signaling differentially regulates the development of the two programs. The findings from the study show that CD235a is expressed by KDR+ primitive progenitors that are induced by the combination of activin-nodal signaling and inhibition of the Wnt-β-catenin pathway. Conversely, the KDR+ cells that lack CD235a expression represent the definitive hematopoietic progenitors that are dependent on Wnt-β-catenin signaling for their development.
With these advances, it is now possible to generate hPSC-derived populations consisting entirely of the primitive or definitive hematopoiesis. Access to enriched definitive hematopoietic populations will greatly facilitate the search for HSCs.
This study was supported by the National Institutes of Health, the Canadian Institutes of Health Research and the Princess Margaret Cancer Foundation. G Keller is a Tier 1 Canada Research Chair in Embryonic Stem Cell Biology.
Wnt signaling controls the specification of definitive and primitive hematopoiesis from human pluripotent stem cells. Sturgeon CM, Ditadi A, Awong G, Kennedy M, Keller G. Nat Biotechnol. 2014 May 18. [Abstract]
Ontario Court Rules on Human Tissue Ownership
An Ontario court has made an unprecedented ruling, which states that any excised human tissue is considered the private property of the institution at which it is held and no longer belongs to person from which it was harvested. While this is the first ruling in Canada to recognize the rights of an institution in the ownership of collected tissues, a number of US courts have already adjudicated that patients lose any rights over excised tissue. This ruling will likely have important implications for stem cell researchers and biotech companies in Ontario.
An Ontario court has made an unprecedented ruling, which states that any excised human tissue is considered the private property of the institution at which it is held and no longer belongs to person from which it was harvested. While this is the first ruling in Canada to recognize the rights of an institution in the ownership of collected tissues, a number of US courts have already adjudicated that patients lose any rights over excised tissue. This ruling will likely have important implications for stem cell researchers and biotech companies in Ontario.
Canada-wide Initiative Launched to Support Regenerative Medicine Research
 A major initiative aimed at supporting the growth of Canada’s regenerative medicine research community was recently launched with more than $1.5M in funding from the Networks of Centres of Excellence of Canada. The network, which has been named CellCAN, is based at the Maisonneuve-Rosement Hospital in Montreal and is led by Dr. Denis Claude Roy. It will link the facilities and resources from institutions across Canada, including UHN’s Orsino Cell Therapy Translational Research Laboratory led by Dr. Armand Keating.
A major initiative aimed at supporting the growth of Canada’s regenerative medicine research community was recently launched with more than $1.5M in funding from the Networks of Centres of Excellence of Canada. The network, which has been named CellCAN, is based at the Maisonneuve-Rosement Hospital in Montreal and is led by Dr. Denis Claude Roy. It will link the facilities and resources from institutions across Canada, including UHN’s Orsino Cell Therapy Translational Research Laboratory led by Dr. Armand Keating.
|
Recent Publications
Prognostic factors for cure, recurrence and long-term survival after surgical resection of thymoma. Safieddine N, Liu G, Cuningham K, Ming T, Hwang D, Brade A, Bezjak A, Fischer S, Xu W, Azad S, Cypel M, Darling G, Yasufuku K, Pierre A, de Perrot M, Waddell T, Keshavjee S. J Thorac Oncol. 2014 Jul. [Abstract] Tumor extravasation following a cement augmentation procedure for vertebral compression fracture in metastatic spinal disease. Cruz JP, Sahgal A, Whyne C, Fehlings MG, Smith R. J Neurosurg Spine. 2014 Jun 6. [Abstract] BDNF signaling in the VTA links the drug-dependent state to drug withdrawal aversions. Vargas-Perez H, Bahi A, Bufalino MR, Ting-A-Kee R, Maal-Bared G, Lam J, Fahmy A, Clarke L, Blanchard JK, Larsen BR, Steffensen S, Dreyer JL, van der Kooy D. J Neurosci. 2014 Jun 4. [Abstract] A microgroove patterned multiwell cell culture plate for high-throughput studies of cell alignment. Lücker PB, Javaherian S, Soleas JP, Halverson D, Zandstra PW, McGuigan AP. Biotechnol Bioeng. 2014 Jun 2. [Abstract] Cell and biomolecule delivery for tissue repair and regeneration in the central nervous system. Donaghue IE, Tam R, Sefton MV, Shoichet MS. J Control Release. 2014 May 27. [Abstract] Tumor archaeology: tracking leukemic evolution to its origins. Dick JE. Transl Med Sci. 2014 May 28. [Abstract] Enhanced proliferation and altered calcium handling in RGS2-deficient vascular smooth muscle cells. Momen A, Afroze T, Sadi AM, Khoshbin A, Zhang H, Choi J, Gu S, Zaidi SH, Heximer SP, Husain M. J Recept Signal Transduct Res. 2014 May 20. [Abstract] Delayed administration of a bio-engineered zinc-finger VEGF-A gene therapy is neuroprotective and attenuates allodynia following traumatic spinal cord injury. Figley SA, Liu Y, Karadimas SK, Satkunendrarajah K, Fettes P, Spratt SK, Lee G, Ando D, Surosky R, Giedlin M, Fehlings MG. PLoS One. 2014 May 20. [Abstract] Wnt signaling controls the specification of definitive and primitive hematopoiesis from human pluripotent stem cells. Sturgeon CM, Ditadi A, Awong G, Kennedy M, Keller G. Nat Biotechnol. 2014 Jun. [Abstract] Very high resolution ultrasound imaging for real-time quantitative visualisation of vascular disruption after spinal cord injury. Soubeyrand M, Badner A, Vawda R, Chung YS, Fehlings M. J Neurotrauma. 2014 May 16. [Abstract] |
The McEwen Centre for Regenerative Medicine, led by director Dr. Gordon Keller, includes 15 scientists at the University of Toronto and five Toronto hospitals, working to advance the development of more effective treatments for conditions including heart disease, diabetes, respiratory disease and spinal cord injury.
The Centre is located at University Health Network, MaRS Centre, Toronto Medical Discovery Tower, 101 College Street, 8th Floor, Room 701, Toronto, Ontario, Canada M5G 1L7
Email: mcewencentre@uhn.ca
Feedback/To Unsubscribe
McEwen Monthly is brought to you by the McEwen Centre for Regenerative Medicine and UHN Research Communications. We hope you have enjoyed receiving this message. If you have any feedback, or if you would prefer to receive the newsletter in text format, please email mkinyanj@uhnresearch.ca.
Some images adapted from the image archives of Wikimedia commons.